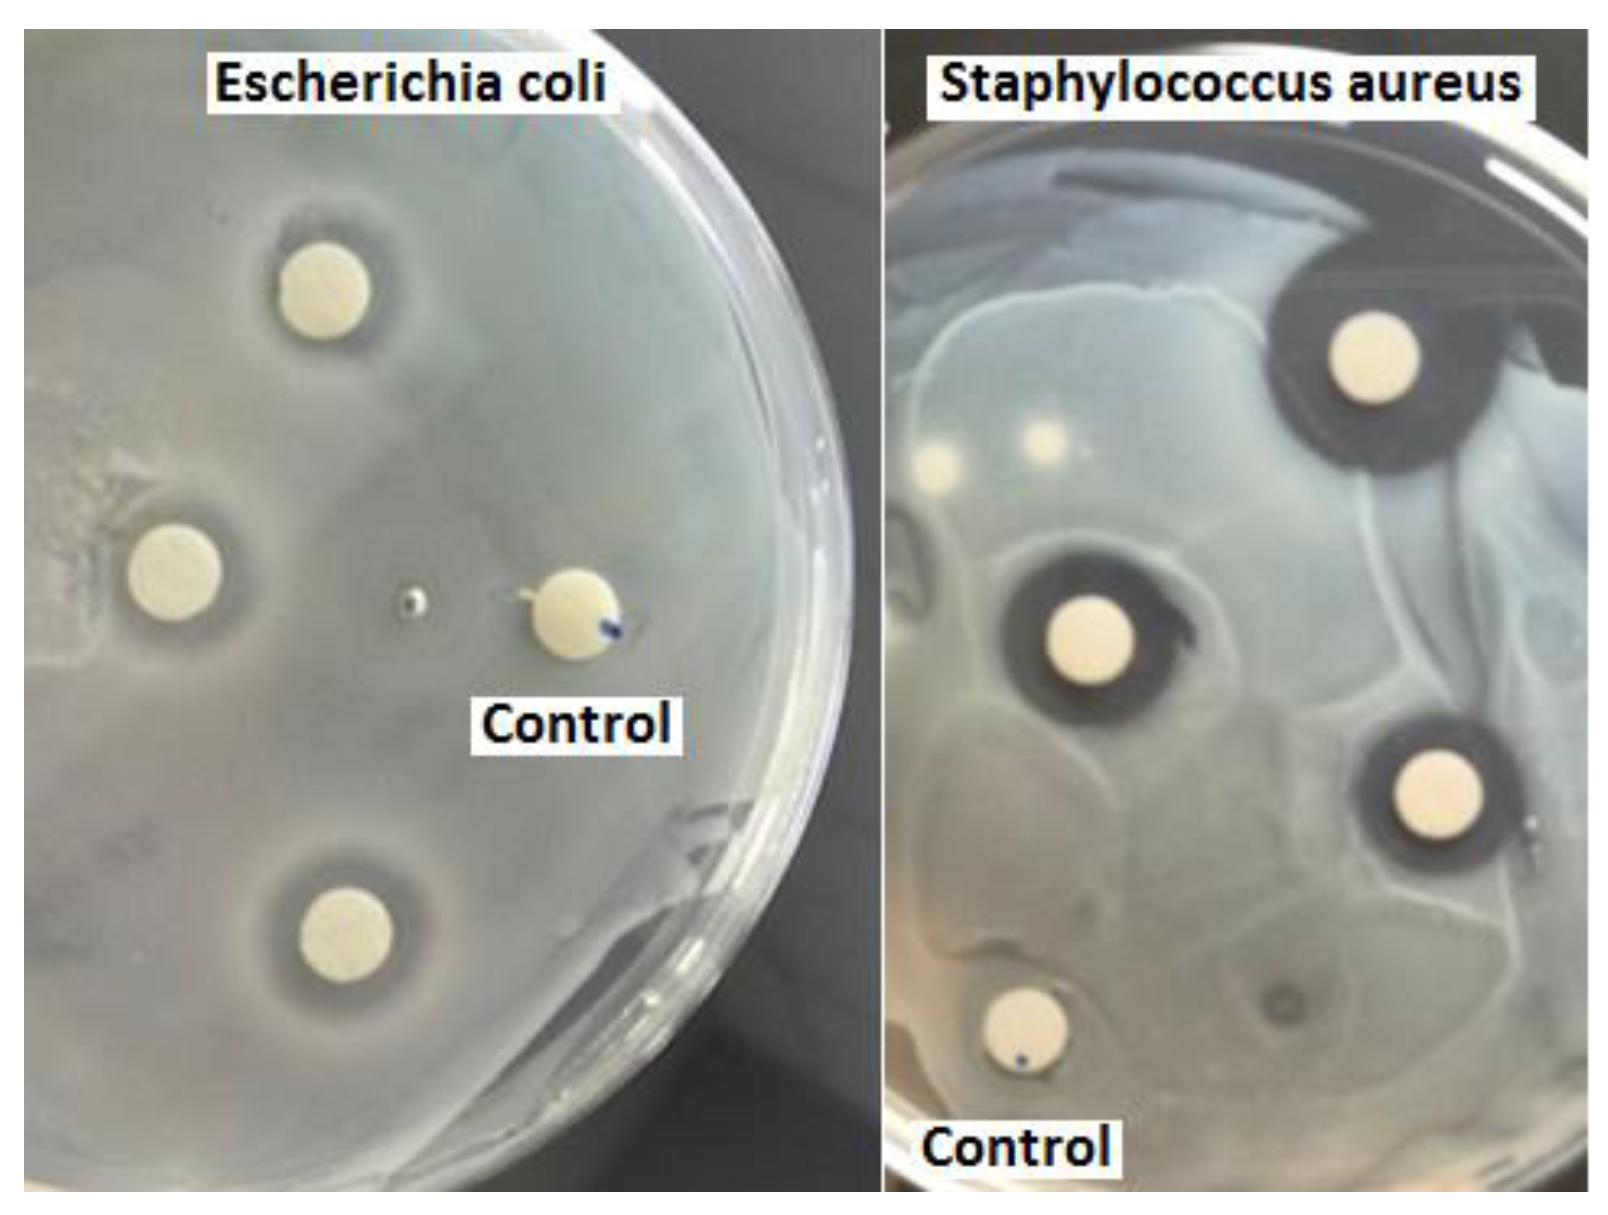
Membranes 08 00038 g002

Texas Sour Orange Juice Used in Scaffolds for Tissue Engineering
Abstract
1. Introduction
2. Materials and Characterization Techniques
2.1. Materials and Methods
2.2. Fabrication of Fine Fiber Membranes
2.3. Antibacterial Test and Dilution Method
2.4. Cell Proliferation and Cell Viability (MTT Assay)
3. Results and Discussion
3.1. Fiber Morphology
3.2. Antibacterial Results
3.3. Cell Proliferation and Viability
4. Conclusions
Author Contributions
Funding
Conflicts of Interest
References
- Chowdhry, M.; Chen, A.F. Wound dressings for primary and revision total joint arthroplasty. Ann. Transl. Med. 2015, 3, 268. [Google Scholar] [CrossRef] [PubMed]
- Moutsatsou, P.; Coopman, K.; Georgiadou, S. Biocompatibility assessment of conducting PANI/Chitosan nanofibers for wound healing applications. Polymers 2017, 9, 687. [Google Scholar] [CrossRef]
- Abrigo, M.; McArthur, S.L.; Kingshott, P. Electrospun nanofibers as dressings for chronic wound care: Advances, challenges, and future prospects. Macromol. Biosci. 2014, 14, 772–792. [Google Scholar] [CrossRef] [PubMed]
- Kanani, A.G.; Bahrami, S.H. Review on electrospun nanofibers scaffold and biomedical applications. Trends Biomater. Artif. Organs 2010, 24, 93–115. [Google Scholar] [CrossRef]
- Zahedi, P.; Rezaeian, I.; Ranaei-Siadat, S.O.; Jafari, S.H.; Supaphol, P. A review on wound dressings with an emphasis on electrospun nanofibrous polymeric bandages. Polym. Adv. Technol. 2010, 21, 77–95. [Google Scholar] [CrossRef]
- Dubský, M.; Kubinová, Š.; Širc, J.; Voska, L.; Zajíček, R.; Zajícová, A.; Lesný, P.; Jirkovská, A.; Michálek, J.; Munzarová, M. Nanofibers prepared by needleless electrospinning technology as scaffolds for wound healing. J. Mater. Sci. Mater. Med. 2012, 23, 931–941. [Google Scholar] [CrossRef] [PubMed]
- Huang, Z.-M.; Zhang, Y.-Z.; Kotaki, M.; Ramakrishna, S. A review on polymer nanofibers by electrospinning and their applications in nanocomposites. Compos. Sci. Technol. 2003, 63, 2223–2253. [Google Scholar] [CrossRef]
- Frenot, A.; Chronakis, I.S. Polymer nanofibers assembled by electrospinning. Curr. Opin. Colloid Interface Sci. 2003, 8, 64–75. [Google Scholar] [CrossRef]
- Rieger, K.A.; Birch, N.P.; Schiffman, J.D. Designing electrospun nanofiber mats to promote wound healing–a review. J. Mater. Chem. B 2013, 1, 4531–4541. [Google Scholar] [CrossRef]
- Lozano, K.; Sarkar, K. Superfine Fiber Creating Spinneret and Uses Thereof. US Patent 8,828,294, 9 September 2014. [Google Scholar]
- Xu, F.; Weng, B.; Materon, L.A.; Kuang, A.; Trujillo, J.A.; Lozano, K. Fabrication of cellulose fine fiber based membranes embedded with silver nanoparticles via Forcespinning. J. Polym. Eng. 2016, 36, 269–278. [Google Scholar] [CrossRef]
- Cremar, L.; Gutierrez, J.; Martinez, J.; Materon, L.; Gilkerson, R.; Xu, F.; Lozano, K. Development of antimicrobial chitosan based nanofiber dressings for wound healing applications. Nanomed. J. 2018, 5, 6–14. [Google Scholar] [CrossRef]
- Stojanovska, E.; Kurtulus, M.; Abdelgawad, A.; Candan, Z.; Kilic, A. Developing lignin-based bio-nanofibers by centrifugal spinning technique. Int. J. Biol. Macromol. 2018, 113, 98–105. [Google Scholar] [CrossRef] [PubMed]
- Xu, F.; Weng, B.; Gilkerson, R.; Materon, L.A.; Lozano, K. Development of tannic acid/chitosan/pullulan composite nanofibers from aqueous solution for potential applications as wound dressing. Carbohydr. Polym. 2015, 115, 16–24. [Google Scholar] [CrossRef] [PubMed]
- Simões, D.; Miguel, S.P.; Ribeiro, M.P.; Coutinho, P.; Mendonça, A.G.; Correia, I.J. Recent advances on antimicrobial wound dressing: A review. Eur. J. Pharm. Biopharm. 2018, 127, 130–141. [Google Scholar] [CrossRef] [PubMed]
- Sheikh, F.A.; Kanjwal, M.A.; Saran, S.; Chung, W.-J.; Kim, H. Polyurethane nanofibers containing copper nanoparticles as future materials. Appl. Surf. Sci. 2011, 257, 3020–3026. [Google Scholar] [CrossRef]
- Ghanbari, H.; Cousins, B.G.; Seifalian, A.M. A nanocage for nanomedicine: Polyhedral oligomeric silsesquioxane (POSS). Macromol. Rapid Commun. 2011, 32, 1032–1046. [Google Scholar] [CrossRef] [PubMed]
- Vitiello, G.; Pezzella, A.; Calcagno, V.; Silvestri, B.; Raiola, L.; D’Errico, G.; Costantini, A.; Branda, F.; Luciani, G. 5, 6-Dihydroxyindole-2-carboxylic acid–TiO2 charge transfer complexes in the radical polymerization of melanogenic precursor(s). J. Phys. Chem. C 2016, 120, 6262–6268. [Google Scholar] [CrossRef]
- Panzella, L.; Melone, L.; Pezzella, A.; Rossi, B.; Pastori, N.; Perfetti, M.; D’Errico, G.; Punta, C.; d’Ischia, M. Surface-functionalization of nanostructured cellulose aerogels by solid state eumelanin coating. Biomacromolecules 2016, 17, 564–571. [Google Scholar] [CrossRef] [PubMed]
- Xu, C.; Xu, F.; Wang, B.; Lu, T. Electrospinning of poly (ethylene-co-vinyl alcohol) nanofibres encapsulated with Ag nanoparticles for skin wound healing. J. Nanomater. 2011, 2011. [Google Scholar] [CrossRef]
- Li, C.; Fu, R.; Yu, C.; Li, Z.; Guan, H.; Hu, D.; Zhao, D.; Lu, L. Silver nanoparticle/chitosan oligosaccharide/poly (vinyl alcohol) nanofibers as wound dressings: A preclinical study. Int. J. Nanomed. 2013, 8, 4131. [Google Scholar] [CrossRef]
- Chen, J.-P.; Chiang, Y. Bioactive electrospun silver nanoparticles-containing polyurethane nanofibers as wound dressings. J. Nanosci. Nanotechnol. 2010, 10, 7560–7564. [Google Scholar] [CrossRef] [PubMed]
- Sheikh, F.A.; Barakat, N.A.; Kanjwal, M.A.; Chaudhari, A.A.; Jung, I.-H.; Lee, J.H.; Kim, H.Y. Electrospun antimicrobial polyurethane nanofibers containing silver nanoparticles for biotechnological applications. Macromol. Res. 2009, 17, 688–696. [Google Scholar] [CrossRef]
- Hong, K.H.; Park, J.L.; Sul, I.H.; Youk, J.H.; Kang, T.J. Preparation of antimicrobial poly (vinyl alcohol) nanofibers containing silver nanoparticles. J. Polym. Sci. Part B Polym. Phys. 2006, 44, 2468–2474. [Google Scholar] [CrossRef]
- Dubey, P.; Bhushan, B.; Sachdev, A.; Matai, I.; Kumar, S.U.; Gopinath, P. Silver-nanoparticle-incorporated composite nanofibers for potential wound-dressing applications. J. Appl. Polym. Sci. 2015, 132. [Google Scholar] [CrossRef]
- Xing, Z.-C.; Chae, W.-P.; Baek, J.-Y.; Choi, M.-J.; Jung, Y.; Kang, I.-K. In vitro assessment of antibacterial activity and cytocompatibility of silver-containing PHBV nanofibrous scaffolds for tissue engineering. Biomacromolecules 2010, 11, 1248–1253. [Google Scholar] [CrossRef] [PubMed]
- Jamnongkan, T.; Sukumaran, S.K.; Sugimoto, M.; Hara, T.; Takatsuka, Y.; Koyama, K. Towards novel wound dressings: Antibacterial properties of zinc oxide nanoparticles and electrospun fiber mats of zinc oxide nanoparticle/poly (vinyl alcohol) hybrids. J. Polym. Eng. 2015, 35, 575–586. [Google Scholar] [CrossRef]
- Kumar, P.S.; Lakshmanan, V.-K.; Anilkumar, T.; Ramya, C.; Reshmi, P.; Unnikrishnan, A.; Nair, S.V.; Jayakumar, R. Flexible and microporous chitosan hydrogel/nano ZnO composite bandages for wound dressing: In vitro and in vivo evaluation. ACS Appl. Mater. Interfaces 2012, 4, 2618–2629. [Google Scholar] [CrossRef] [PubMed]
- Wang, W.; Li, Z.; Zheng, W.; Yang, J.; Zhang, H.; Wang, C. Electrospun palladium (IV)-doped copper oxide composite nanofibers for non-enzymatic glucose sensors. Electrochem. Commun. 2009, 11, 1811–1814. [Google Scholar] [CrossRef]
- Haider, A.; Kwak, S.; Gupta, K.C.; Kang, I.-K. Antibacterial activity and cytocompatibility of PLGA/CuO hybrid nanofiber scaffolds prepared by electrospinning. J. Nanomater. 2015, 16, 107. [Google Scholar] [CrossRef]
- Jao, W.C.; Yang, M.C.; Lin, C.H.; Hsu, C.C. Fabrication and characterization of electrospun silk fibroin/TiO2 nanofibrous mats for wound dressings. Polym. Adv. Technol. 2012, 23, 1066–1076. [Google Scholar] [CrossRef]
- Chen, Y.; Yan, L.; Yuan, T.; Zhang, Q.; Fan, H. Asymmetric polyurethane membrane with in situ-generated nano-TiO2 as wound dressing. J. Appl. Polym. Sci. 2011, 119, 1532–1541. [Google Scholar] [CrossRef]
- Yan, L.; Si, S.; Chen, Y.; Yuan, T.; Fan, H.; Yao, Y.; Zhang, Q. Electrospun in-situ hybrid polyurethane/nano-TiO2 as wound dressings. Fibers Polym. 2011, 12, 207–213. [Google Scholar] [CrossRef]
- Dhandayuthapani, B.; Poulose, A.C.; Nagaoka, Y.; Hasumura, T.; Yoshida, Y.; Maekawa, T.; Kumar, D.S. Biomimetic smart nanocomposite: In vitro biological evaluation of zein electrospun fluorescent nanofiber encapsulated CdS quantum dots. Biofabrication 2012, 4, 025008. [Google Scholar] [CrossRef] [PubMed]
- Bagherzadeh, R.; Latifi, M.; Najar, S.S.; Tehran, M.A.; Kong, L. The application of Cd Se/ZnS quantum dots and confocal laser scanning microscopy for three-dimensional imaging of nanofibrous structures. J. Ind. Text. 2014, 43, 496–510. [Google Scholar] [CrossRef]
- Percival, S.L.; Bowler, P.; Russell, D. Bacterial resistance to silver in wound care. J. Hosp. Infect. 2005, 60, 1–7. [Google Scholar] [CrossRef] [PubMed]
- Kandhasamy, S.; Perumal, S.; Madhan, B.; Umamaheswari, N.; Banday, J.A.; Perumal, P.T.; Santhanakrishnan, V.P. Synthesis and Fabrication of Collagen-Coated Ostholamide Electrospun Nanofiber Scaffold for Wound Healing. ACS Appl. Mater. Interfaces 2017, 9, 8556–8568. [Google Scholar] [CrossRef] [PubMed]
- Zhang, W.; Ronca, S.; Mele, E. Electrospun nanofibres containing antimicrobial plant extracts. Nanomaterials 2017, 7, 42. [Google Scholar] [CrossRef] [PubMed]
- Yao, C.H.; Yeh, J.Y.; Chen, Y.S.; Li, M.H.; Huang, C.H. Wound-healing effect of electrospun gelatin nanofibres containing Centella asiatica extract in a rat model. J. Tissue Eng. Regen. Med. 2017, 11, 905–915. [Google Scholar] [CrossRef] [PubMed]
- Chan, W.P.; Huang, K.C.; Bai, M.Y. Silk fibroin protein-based nonwoven mats incorporating baicalein Chinese herbal extract: Preparation, characterizations, and in vivo evaluation. J. Biomed. Mater. Res. Part B Appl. Biomater. 2017, 105, 420–430. [Google Scholar] [CrossRef] [PubMed]
- Dashdorj, U.; Reyes, M.K.; Unnithan, A.R.; Tiwari, A.P.; Tumurbaatar, B.; Park, C.H.; Kim, C.S. Fabrication and characterization of electrospun zein/Ag nanocomposite mats for wound dressing applications. Int. J. Biol. Macromol. 2015, 80, 1–7. [Google Scholar] [CrossRef] [PubMed]
- Lin, J.; Li, C.; Zhao, Y.; Hu, J.; Zhang, L.-M. Co-electrospun nanofibrous membranes of collagen and zein for wound healing. ACS Appl. Mater. Interfaces 2012, 4, 1050–1057. [Google Scholar] [CrossRef] [PubMed]
- Sarhan, W.A.; Azzazy, H.M.; El-Sherbiny, I.M. Honey/chitosan nanofiber wound dressing enriched with Allium sativum and Cleome droserifolia: Enhanced antimicrobial and wound healing activity. ACS Appl. Mater. Interfaces 2016, 8, 6379–6390. [Google Scholar] [CrossRef] [PubMed]
- Xu, Q.; Chen, L.-L.; Ruan, X.; Chen, D.; Zhu, A.; Chen, C.; Bertrand, D.; Jiao, W.-B.; Hao, B.-H.; Lyon, M.P. The draft genome of sweet orange (Citrus sinensis). Nat. Genet. 2013, 45, 59. [Google Scholar] [CrossRef] [PubMed]
- Herath, H.; Chamikara, M.; Dissanayake, D.; Dissanayake, M.; Ishan, M.; Rajapakse, S.; Sooriyapathirana, S. A comparative assessment of the antibacterial activity in fruit juice of Sri Lankan sweet orange cultivars vis a vis sour orange. J. Agric. Sci. 2016, 11, 13–23. [Google Scholar] [CrossRef]
- Shrestha, N.; Shrestha, S.; Bhattarai, A. Determination of ascorbic acid in different citrus fruits of Kathmandu Valley. J. Med. Biol. Sci. Res. 2016, 2, 9–14. [Google Scholar]
- Okeke, M.I.; Okoli, A.S.; Eze, E.N.; Ekwume, G.C.; Okosa, E.U.; Iroegbu, C.U. Antibacterial activity of Citrus limonum fruit juice extract. Pak. J. Pharm. Sci. 2015, 28, 1567–1571. [Google Scholar] [PubMed]
- Azhdarzadeh, F.; Hojjati, M. Chemical composition and antimicrobial activity of leaf, ripe and unripe peel of bitter orange (Citrus aurantium) essential oils. Nutr. Food Sci. Res. 2016, 3, 43–50. [Google Scholar] [CrossRef]
- Caccioni, D.R.; Guizzardi, M.; Biondi, D.M.; Renda, A.; Ruberto, G. Relationship between volatile components of citrus fruit essential oils and antimicrobial action on Penicillium digitatum and Penicillium italicum. Int. J. Food Microbiol. 1998, 43, 73–79. [Google Scholar] [CrossRef]
- Okamoto, M.; John, B. Synthetic biopolymer nanocomposites for tissue engineering scaffolds. Prog. Polym. Sci. 2013, 38, 1487–1503. [Google Scholar] [CrossRef]
- Huang, J.C.; Shetty, A.S.; Wang, M.S. Biodegradable plastics: A review. Adv. Polym. Technol. 1990, 10, 23–30. [Google Scholar] [CrossRef]
- Slepička, P.; Malá, Z.; Rimpelová, S.; Švorčík, V. Antibacterial properties of modified biodegradable PHB non-woven fabric. Mater. Sci. Eng. C 2016, 65, 364–368. [Google Scholar] [CrossRef] [PubMed]
- Niu, C.; Fan, Z.; Zheng, F.; Li, Y.; Liu, C.; Wang, J.; Li, Q. Isolation and identification of gas-producing spoilage microbes in fermented broad bean paste. Food Control 2018, 84, 8–16. [Google Scholar] [CrossRef]
- Buck, J.D.; Cleverdon, R.C. The spread plate as a method for the enumeration of marine bacteria. Limnol. Oceanogr. 1960, 5, 78–80. [Google Scholar] [CrossRef]
- Abdal-hay, A.; Tijing, L.D.; Lim, J.K. Characterization of the surface biocompatibility of an electrospun nylon 6/CaP nanofiber scaffold using osteoblasts. Chem. Eng. J. 2013, 215, 57–64. [Google Scholar] [CrossRef]
- Abdal-hay, A.; Pant, H.R.; Lim, J.K. Super-hydrophilic electrospun nylon-6/hydroxyapatite membrane for bone tissue engineering. Eur. Polym. J. 2013, 49, 1314–1321. [Google Scholar] [CrossRef]
- Ignatova, M.; Manolova, N.; Rashkov, I. Novel antibacterial fibers of quaternized chitosan and poly (vinyl pyrrolidone) prepared by electrospinning. Eur. Polym. J. 2007, 43, 1112–1122. [Google Scholar] [CrossRef]
- Karabıyıklı, Ş.; Değirmenci, H.; Karapınar, M. Inhibitory effect of sour orange (Citrus aurantium) juice on Salmonella Typhimurium and Listeria monocytogenes. LWT Food Sci. Technol. 2014, 55, 421–425. [Google Scholar] [CrossRef]
- Arkoun, M.; Daigle, F.; Heuzey, M.C.; Ajji, A. Antibacterial electrospun chitosan-based nanofibers: A bacterial membrane perforator. Food Sci. Nutr. 2017, 5, 865–874. [Google Scholar] [CrossRef] [PubMed]
- Picard, M.; Ritchie, D.; Wright, K.J.; Romestaing, C.; Thomas, M.M.; Rowan, S.L.; Taivassalo, T.; Hepple, R.T. Mitochondrial functional impairment with aging is exaggerated in isolated mitochondria compared to permeabilized myofibers. Aging Cell 2010, 9, 1032–1046. [Google Scholar] [CrossRef] [PubMed]
- Sundaramurthi, D.; Krishnan, U.M.; Sethuraman, S. Electrospun nanofibers as scaffolds for skin tissue engineering. Polym. Rev. 2014, 54, 348–376. [Google Scholar] [CrossRef]

© 2018 by the authors. Licensee MDPI, Basel, Switzerland. This article is an open access article distributed under the terms and conditions of the Creative Commons Attribution (CC BY) license (http://creativecommons.org/licenses/by/4.0/).
Share and Cite
Akia, M.; Salinas, N.; Rodriguez, C.; Gilkerson, R.; Materon, L.; Lozano, K. Texas Sour Orange Juice Used in Scaffolds for Tissue Engineering. Membranes 2018, 8, 38. https://doi.org/10.3390/membranes8030038
Akia M, Salinas N, Rodriguez C, Gilkerson R, Materon L, Lozano K. Texas Sour Orange Juice Used in Scaffolds for Tissue Engineering. Membranes. 2018; 8(3):38. https://doi.org/10.3390/membranes8030038
Chicago/Turabian StyleAkia, Mandana, Nataly Salinas, Cristobal Rodriguez, Robert Gilkerson, Luis Materon, and Karen Lozano. 2018. "Texas Sour Orange Juice Used in Scaffolds for Tissue Engineering" Membranes 8, no. 3: 38. https://doi.org/10.3390/membranes8030038
APA StyleAkia, M., Salinas, N., Rodriguez, C., Gilkerson, R., Materon, L., & Lozano, K. (2018). Texas Sour Orange Juice Used in Scaffolds for Tissue Engineering. Membranes, 8(3), 38. https://doi.org/10.3390/membranes8030038

